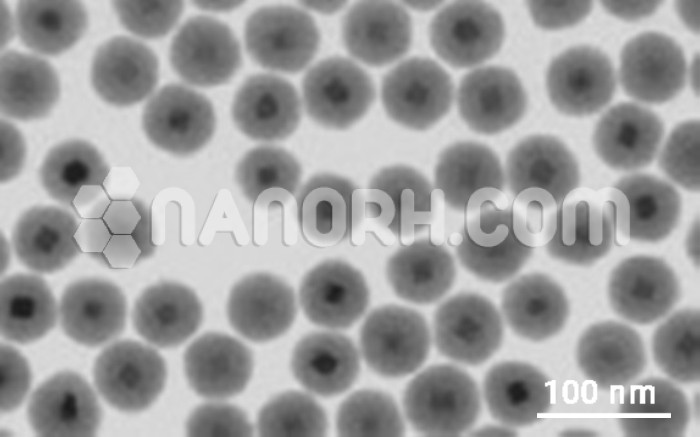
Ag Ag2Se Core Shell Nanoparticles Ag Ag2Se Core Shell Nanoparticles

| Ag Ag2Se Core Shell Nanoparticles | |
| Product No | NRE-16082 |
| CAS No. | 1302-09-6 |
| Formula | Ag/Ag2Se |
| Average diameter | 30-50nm |
| Average Length | up to 200µm |
| Purity | 99.9% |
| Molecular Weight | 294.6964 g/mol |
| Density | 8.22 g/cm3 |
| Melting Point | 896.85 °C |
| Boiling Point | NA |
Ag Ag2Se Core-Shell Nanoparticles
Properties
Ag Ag₂Se core-shell nanoparticles combine the unique properties of silver (Ag) and silver selenide (Ag₂Se), which give these materials a diverse range of functional attributes. The core-shell structure enhances the properties of both materials, resulting in a hybrid nanoparticle with a combination of optical, electronic, and chemical behaviors.
Optical Properties
Plasmonic Behavior (Silver Core): The silver core exhibits strong surface plasmon resonance (SPR), which is a collective oscillation of free electrons in response to light. This can be tuned to specific wavelengths by adjusting the nanoparticle size or shape. SPR makes Ag/Ag₂Se nanoparticles useful in applications like surface-enhanced Raman spectroscopy (SERS) and biosensing.
Optical Absorption: The silver selenide shell adds to the optical properties, especially in the infrared and mid-infrared regions. The band gap of Ag₂Se is small (around 0.1 to 0.3 eV), making it sensitive to light in the infrared region, which can be beneficial for photodetectors and optical switches.
Electrical Properties
Conductivity (Silver Core): Silver has excellent electrical conductivity, which is crucial for applications where the nanoparticle is involved in electron transport or conductive coatings.
Semiconducting Behavior (Ag₂Se Shell): The silver selenide shell has semiconducting properties with a tunable band gap, typically ranging from 0.1 to 0.3 eV depending on the particle size. This allows for control over charge transport, making Ag/Ag₂Se nanoparticles suitable for applications that require electronic properties, such as photovoltaics and sensors.
Thermal Properties
Thermoelectric Efficiency (Ag₂Se Shell): Ag₂Se is known for its low thermal conductivity and relatively high electrical conductivity, which makes it a promising material for thermoelectric applications (converting heat into electricity).
Chemical Properties
Stability and Passivation: The Ag₂Se shell can protect the silver core from oxidation, increasing the chemical stability of the nanoparticle compared to pure silver. This enhances the nanoparticle’s durability in various environments (e.g., aqueous solutions, high temperatures).
Antibacterial Activity (Silver Core): The silver core imparts antimicrobial properties, making these nanoparticles useful in biocidal applications such as wound healing or water purification.
Morphological Properties
Core-Shell Structure: The core-shell architecture allows for controlled modulation of the size and composition of the individual layers. This control can fine-tune the properties of the nanoparticles, enabling applications in a variety of fields. The shell thickness, particle size, and the ratio of core to shell can be adjusted during synthesis to optimize specific properties.